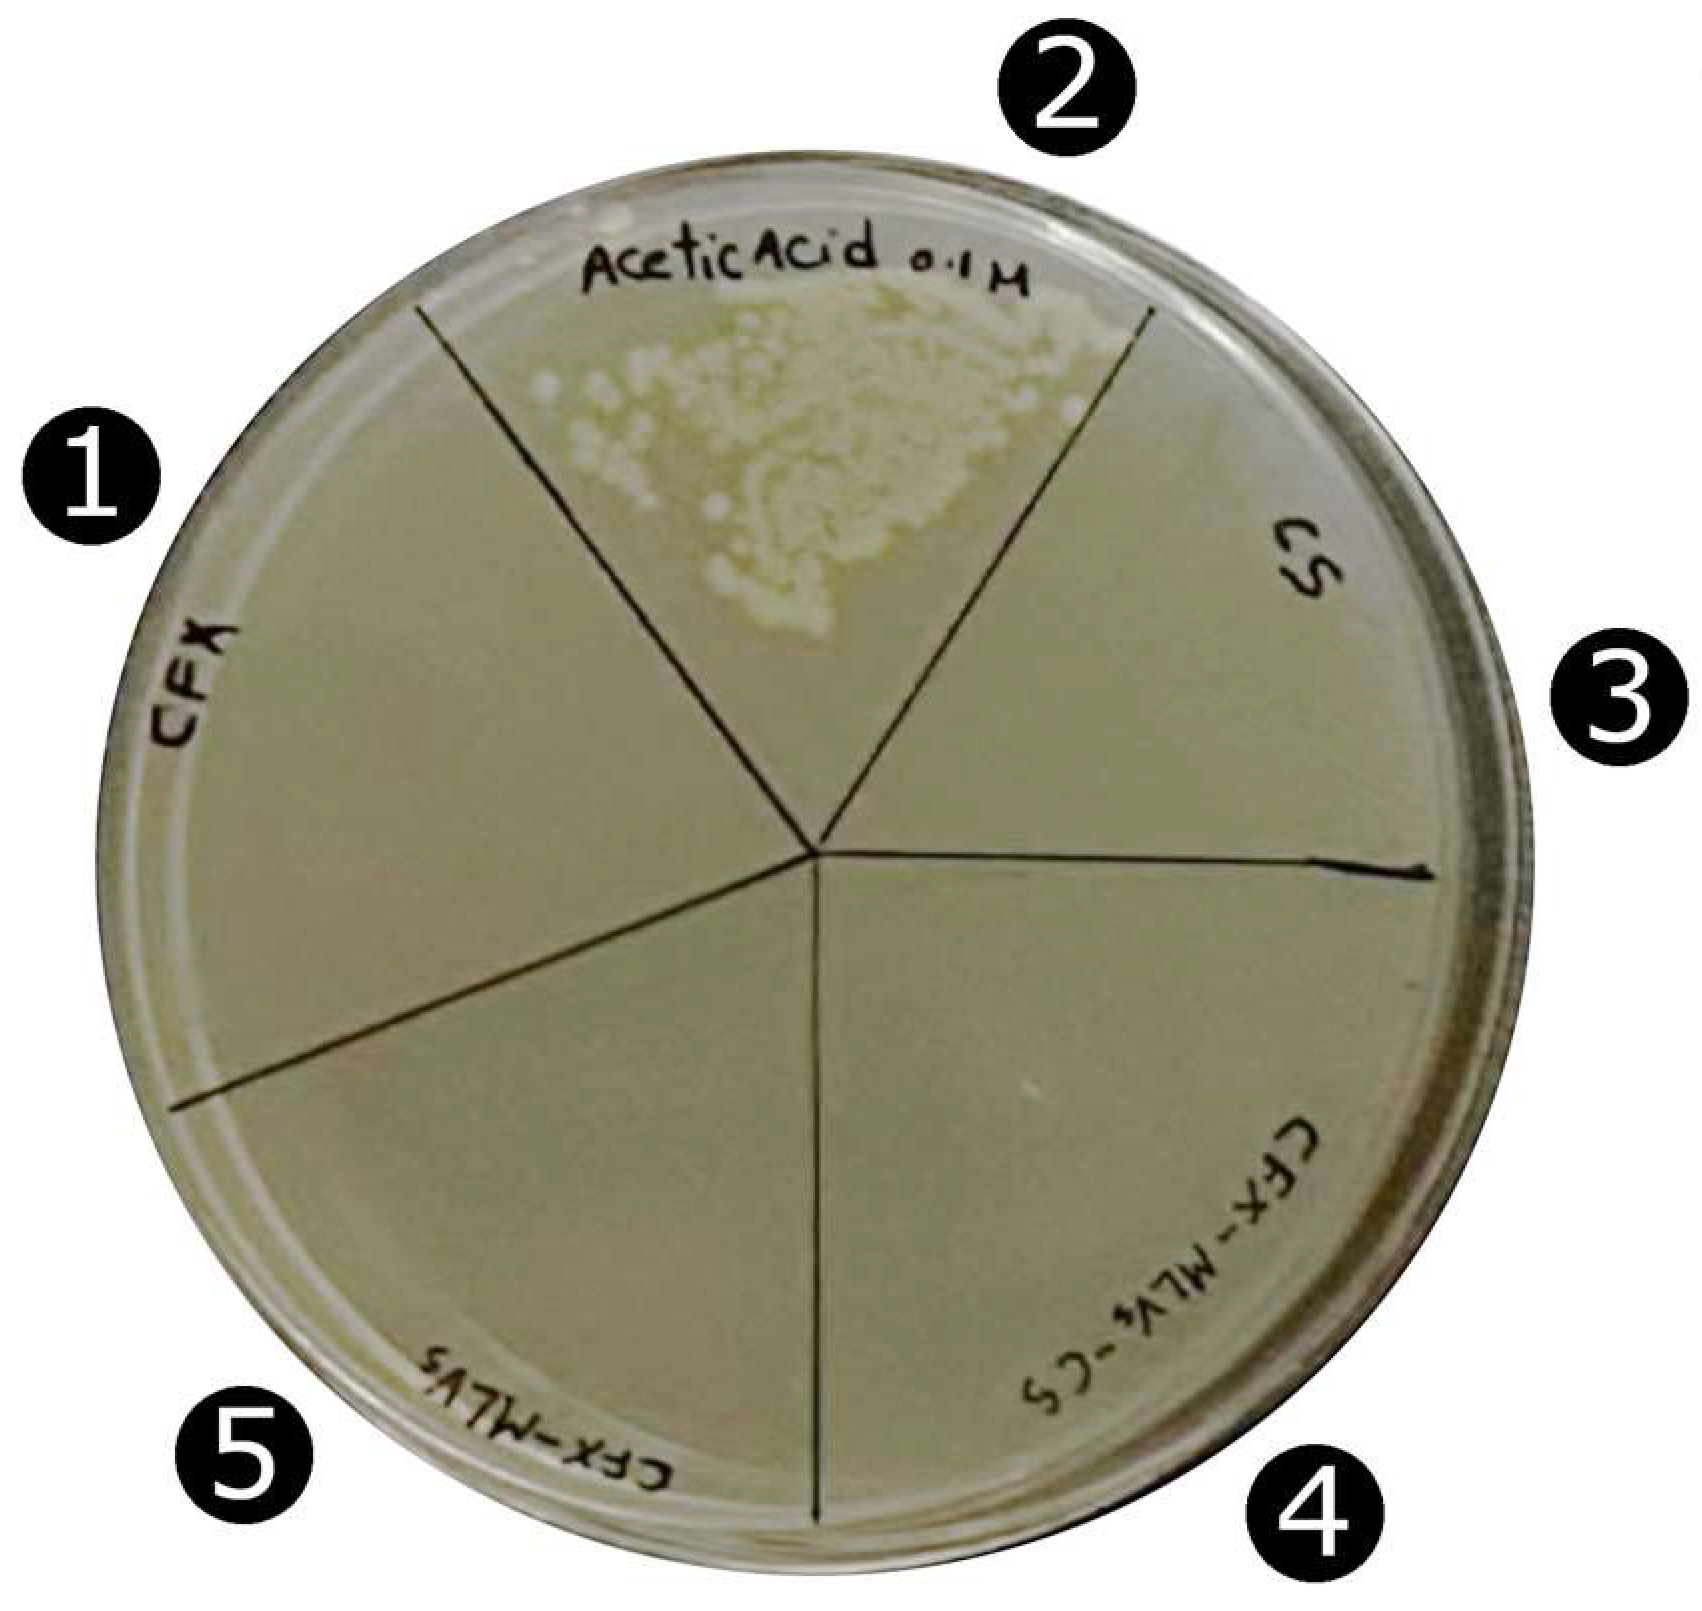
Pharmaceutics 16 01036 g003

Chitosan-Coated Liposome Formulations for Encapsulation of Ciprofloxacin and Etoposide
Abstract
1. Introduction
2. Materials and Methods
2.1. Materials
2.2. Methods
2.2.1. Liposome Preparation for Hydrophilic Drug Encapsulation
2.2.2. Liposome Preparation for Hydrophobic Drug Encapsulation
2.2.3. CS-Coated Liposomes Preparation
2.2.4. Characterisation of Synthesised Particles
ATR-FTIR Analysis
Particle Size and Zeta Potential Measurements
2.2.5. Encapsulation Efficiency and Drug Loading
2.2.6. In Vitro Drug Release
2.2.7. Antimicrobial Activity of CFX-SUVs and CFX-SUVs-CS
2.2.8. In Vitro Cytotoxicity Studies of Eto-CholSUVs and Eto-CholSUVs-CS
2.2.9. Cell Growth Inhibition
2.2.10. Statistical Analysis
3. Results and Discussion
3.1. ATR-FTIR Analysis
3.2. Particle Size and Zeta Potential
3.3. In Vitro CFX Release
3.4. Antimicrobial Activity of CFX-SUVs and CFX-SUVs-CS
3.5. In Vitro Eto Release
3.6. In Vitro Cytotoxicity Studies of Eto-CholSUVs and Eto-CholSUVs-CS
3.7. In Vitro Cell Growth Inhibition in Eto-CholSUVs and Eto-CholSUVs-CS
4. Conclusions
Author Contributions
Funding
Institutional Review Board Statement
Informed Consent Statement
Data Availability Statement
Acknowledgments
Conflicts of Interest
References
- O’Neill, J. Review on Antimicrobial Resistance: Tackling Drug-Resistant Infections Globally: Final Report and Recommendations. 2016, pp. 1–84. Available online: https://amr-review.org/sites/default/files/160525_Final%20paper_with%20cover.pdf (accessed on 8 July 2024).
- World Health Organization. World Health Statistics 2018: Monitoring Health for the SDGs, Sustainable Development Goals; World Health Organization: Geneva, Switzerland, 2018. [Google Scholar]
- Hu, Y.-Q.; Zhang, S.; Xu, Z.; Lv, Z.-S.; Liu, M.-L.; Feng, L.-S. 4-Quinolone hybrids and their antibacterial activities. Eur. J. Med. Chem. 2017, 141, 335–345. [Google Scholar] [CrossRef] [PubMed]
- Hanna, D.H.; Saad, G.R. Encapsulation of ciprofloxacin within modified xanthan gum-chitosan based hydrogel for drug delivery. Bioorg. Chem. 2019, 84, 115–124. [Google Scholar] [CrossRef] [PubMed]
- Loike, J.D.; Horwitz, S.B. Effects of podophyllotoxin and VP-16-213 on microtubule assembly in vitro and nucleoside transport in HeLa cells. Biochemistry 1976, 15, 5435–5443. [Google Scholar] [CrossRef] [PubMed]
- Hande, K. Etoposide: Four decades of development of a topoisomerase II inhibitor. Eur. J. Cancer 1998, 34, 1514–1521. [Google Scholar] [CrossRef] [PubMed]
- Al-Ghabkari, A.; Huang, B.; Park, M. Aberrant MET Receptor Tyrosine Kinase Signaling in Glioblastoma: Targeted Therapy and Future Directions. Cells 2024, 13, 218. [Google Scholar] [CrossRef] [PubMed]
- van der Meulen, M.; Chahal, M.; Mason, W.P. The Value of Etoposide for Recurrent Glioma. Can. J. Neurol. Sci./J. Can. Des Sci. Neurol. 2023, 1–4. [Google Scholar] [CrossRef] [PubMed]
- Sengupta, S.; Tyagi, P.; Chandra, S.; Kochupillai, V.; Gupta, S. Encapsulation in cationic liposomes enhances antitumour efficacy and reduces the toxicity of etoposide, a topo-isomerase II inhibitor. Pharmacology 2001, 62, 163–171. [Google Scholar] [CrossRef]
- Xing, H.; Hwang, K.; Lu, Y. Recent Developments of Liposomes as Nanocarriers for Theranostic Applications. Theranostics 2016, 6, 1336–1352. [Google Scholar] [CrossRef] [PubMed]
- Lombardo, D.; Kiselev, M. Methods of Liposomes Preparation: Formation and Control Factors of Versatile Nanocarriers for Biomedical and Nanomedicine Application. Pharmaceutics 2022, 14, 543. [Google Scholar] [CrossRef]
- Wang, S.; Chen, Y.; Guo, J.; Huang, Q. Liposomes for Tumor Targeted Therapy: A Review. Int. J. Mol. Sci. 2023, 24, 2643. [Google Scholar] [CrossRef]
- Ferreira, M.; Ogren, M.; Dias, J.; Silva, M.; Gil, S.A.; Tavares, L.; Aires da Silva, F.; Gaspar, M.; Aguiar, S. Liposomes as Antibiotic Delivery Systems: A Promising Nanotechnological Strategy against Antimicrobial Resistance. Molecules 2021, 26, 2047. [Google Scholar] [CrossRef] [PubMed]
- Magar, K.T.; Boafo, G.F.; Li, X.; Chen, Z.; He, W. Liposome-based delivery of biological drugs. Chin. Chem. Lett. 2022, 33, 587–596. [Google Scholar] [CrossRef]
- Chen, Y.; Xia, G.; Zhao, Z.; Xue, F.; Gu, Y.; Chen, C.; Zhang, Y. 7,8-Dihydroxyflavone nano-liposomes decorated by crosslinked and glycosylated lactoferrin: Storage stability, antioxidant activity, in vitro release, gastrointestinal digestion and transport in Caco-2 cell monolayers. J. Funct. Foods 2020, 65, 103742. [Google Scholar] [CrossRef]
- Sriwidodo, A.; Umar, A.K.; Wathoni, N.; Zothantluanga, J.H.; Das, S.; Luckanagul, J.A. Liposome-polymer complex for drug delivery system and vaccine stabilization. Heliyon 2022, 8, e08934. [Google Scholar] [CrossRef] [PubMed]
- Madani, F.; Esnaashari, S.S.; Webster, T.J.; Khosravani, M.; Adabi, M. Polymeric nanoparticles for drug delivery in glioblastoma: State of the art and future perspectives. J. Control. Release 2022, 349, 649–661. [Google Scholar] [CrossRef] [PubMed]
- Peter, M.G. Applications and environmental aspects of chitin and chitosan. J. Macromol. Sci. -Pure Appl. Chem. 1995, A32, 629–640. [Google Scholar] [CrossRef]
- Younes, I.; Rinaudo, M. Chitin and Chitosan Preparation from Marine Sources. Structure, Properties and Applications. Mar. Drugs 2015, 13, 1133–1174. [Google Scholar] [CrossRef]
- Dai-Hung, N.; Thanh-Sang, V.; Dai-Nghiep, N.; Kang, K.-H.; Je, J.-Y.; Hoang Nguyen-Duc, P.; Byun, H.-G.; Kim, S.-K. Biological effects of chitosan and its derivatives. Food Hydrocoll. 2015, 51, 200–216. [Google Scholar] [CrossRef]
- Argüelles-Monal, W.M.; Lizardi-Mendoza, J.; Fernandez-Quiroz, D.; Recillas-Mota, M.T.; Montiel-Herrera, M. Chitosan derivatives: Introducing new functionalities with a controlled molecular architecture for innovative materials. Polymers 2018, 10, 33. [Google Scholar] [CrossRef]
- Aranaz, I.; Acosta, N.; Civera, C.; Elorza, B.; Mingo, J.; Castro, C.; Gandia, M.D.; Caballero, A.H. Cosmetics and cosmeceutical applications of chitin, chitosan and their derivatives. Polymers 2018, 10, 25. [Google Scholar] [CrossRef]
- Hemmingsen, L.M.; Panchai, P.; Julin, K.; Basnet, P.; Nystad, M.; Johannessen, M.; Škalko-Basnet, N. Chitosan-based delivery system enhances antimicrobial activity of chlorhexidine. Front. Microbiol. 2022, 13, 1023083. [Google Scholar] [CrossRef] [PubMed]
- Wang, X.; Cheng, F.; Wang, X.; Feng, T.; Xia, S.; Zhang, X. Chitosan decoration improves the rapid and long-term antibacterial activities of cinnamaldehyde-loaded liposomes. Int. J. Biol. Macromol. 2021, 168, 59–66. [Google Scholar] [CrossRef] [PubMed]
- Pu, C.; Tang, W. A chitosan-coated liposome encapsulating antibacterial peptide, Apep10: Characterisation, triggered-release effects and antilisterial activity in thaw water of frozen chicken. Food Funct. 2016, 7, 4310–4322. [Google Scholar] [CrossRef] [PubMed]
- Laverde-Rojas, V.; Liscano, Y.; Rivera-Sánchez, S.P.; Ocampo-Ibáñez, I.D.; Betancourt, Y.; Alhajj, M.J.; Yarce, C.J.; Salamanca, C.H.; Oñate-Garzón, J. Antimicrobial Contribution of Chitosan Surface-Modified Nanoliposomes Combined with Colistin against Sensitive and Colistin-Resistant Clinical Pseudomonas aeruginosa. Pharmaceutics 2021, 13, 41. [Google Scholar] [CrossRef] [PubMed]
- Alshraim, M.O.; Sangi, S.; Harisa, G.I.; Alomrani, A.H.; Yusuf, O.; Badran, M.M. Chitosan-Coated Flexible Liposomes Magnify the Anticancer Activity and Bioavailability of Docetaxel: Impact on Composition. Molecules 2019, 24, 250. [Google Scholar] [CrossRef] [PubMed]
- Hasan, M.; Elkhoury, K.; Belhaj, N.; Kahn, C.; Tamayol, A.; Barberi-Heyob, M.; Arab-Tehrany, E.; Linder, M. Growth-Inhibitory Effect of Chitosan-Coated Liposomes Encapsulating Curcumin on MCF-7 Breast Cancer Cells. Mar. Drugs 2020, 18, 217. [Google Scholar] [CrossRef] [PubMed]
- Alomrani, A.; Badran, M.; Harisa, G.; Alshehry, M.; Alhariri, M.; Alshamsan, A.; Alkholief, M. The use of chitosan-coated flexible liposomes as a remarkable carrier to enhance the antitumor efficacy of 5-fluorouracil against colorectal cancer. Saudi Pharm. J. 2019, 27, 603–611. [Google Scholar] [CrossRef] [PubMed]
- Mazzotta, E.; Marazioti, A.; Mourtas, S.; Muzzalupo, R.; Antimisiaris, S.G. Liposomes Coated with Novel Synthetic Bifunctional Chitosan Derivatives as Potential Carriers of Anticancer Drugs. Pharmaceutics 2024, 16, 319. [Google Scholar] [CrossRef] [PubMed]
- Aranaz, I.; Alcántara, A.R.; Civera, M.C.; Arias, C.; Elorza, B.; Heras Caballero, A.; Acosta, N. Chitosan: An Overview of Its Properties and Applications. Polymers 2021, 13, 3256. [Google Scholar] [CrossRef]
- Abedian, Z.; Moghadamnia, A.A.; Zabihi, E.; Pourbagher, R.; Ghasemi, M.; Nouri, H.R.; Tashakorian, H.; Jenabian, N. Anticancer properties of chitosan against osteosarcoma, breast cancer and cervical cancer cell lines. Casp. J. Intern. Med. 2019, 10, 439. [Google Scholar]
- Rosales-Mendoza, S.; González-Ortega, O.; Rosales-Mendoza, S.; González-Ortega, O. Liposome-Based Nanovaccines. In Nanovaccines: An Innovative Technology to Fight Human and Animal Diseases; Springer: Berlin/Heidelberg, Germany, 2019; pp. 233–265. [Google Scholar]
- Tagami, T.; Ernsting, M.J.; Li, S.-D. Efficient tumor regression by a single and low dose treatment with a novel and enhanced formulation of thermosensitive liposomal doxorubicin. J. Control. Release 2011, 152, 303–309. [Google Scholar] [CrossRef]
- Haeri, A.; Sadeghian, S.; Rabbani, S.; Anvari, M.S.; Ghassemi, S.; Radfar, F.; Dadashzadeh, S. Effective attenuation of vascular restenosis following local delivery of chitosan decorated sirolimus liposomes. Carbohydr. Polym. 2017, 157, 1461–1469. [Google Scholar] [CrossRef]
- Klaseboer, E.; Chan, D.Y.C. On the derivation of the Smoluchowski result of electrophoretic mobility. J. Colloid Interface Sci. 2020, 568, 176–184. [Google Scholar] [CrossRef]
- Ritger, P.L.; Peppas, N.A. A simple equation for description of solute release I. Fickian and non-fickian release from non-swellable devices in the form of slabs, spheres, cylinders or discs. J. Control. Release 1987, 5, 23–36. [Google Scholar] [CrossRef]
- Clinical and Laboratory Standards Institute. Methods for Dilution Antimicrobial Susceptibility Tests for Bacteria that Grow Aerobically; Clinical and Laboratory Standards Institute: Wayne, PA, USA, 2018; p. 112. [Google Scholar]
- He, H.; Lu, Y.; Qi, J.; Zhu, Q.; Chen, Z.; Wu, W. Adapting liposomes for oral drug delivery. Acta Pharm. Sin. B 2019, 9, 36–48. [Google Scholar] [CrossRef] [PubMed]
- Zhang, G.; Zhang, M.; Pei, Y.; Qian, K.; Xie, J.; Huang, Q.; Liu, S.; Xue, N.; Zu, Y.; Wang, H. Enhancing stability of liposomes using high molecular weight chitosan to promote antioxidative stress effects and lipid-lowering activity of encapsulated lutein in vivo and in vitro. Int. J. Biol. Macromol. 2023, 253, 126564. [Google Scholar] [CrossRef] [PubMed]
- Mahato, M.; Sarkar, R.; Pal, P.; Talapatra, G. Formation of silver nanoparticle at phospholipid template using LB technique and its SERS application. Indian J. Phys. 2015, 89, 997–1005. [Google Scholar] [CrossRef]
- Liu, Y.; Zhang, Z.; Lv, H.; Qin, Y.; Deng, L. Surface modification of chitosan film via polydopamine coating to promote biomineralization in bone tissue engineering. J. Bioact. Compat. Polym. 2018, 33, 134–145. [Google Scholar] [CrossRef]
- de Souza Costa-Júnior, E.; Pereira, M.M.; Mansur, H.S. Properties and biocompatibility of chitosan films modified by blending with PVA and chemically crosslinked. J. Mater. Sci. Mater. Med. 2009, 20, 553–561. [Google Scholar] [CrossRef]
- Aranaz, I.; Harris, R.; Navarro-Garcia, F.; Heras, A.; Acosta, N. Chitosan based films as supports for dual antimicrobial release. Carbohydr. Polym. 2016, 146, 402–410. [Google Scholar] [CrossRef]
- Arafa, M.G.; Mousa, H.A.; Afifi, N.N. Preparation of PLGA-chitosan based nanocarriers for enhancing antibacterial effect of ciprofloxacin in root canal infection. Drug Deliv. 2020, 27, 26–39. [Google Scholar] [CrossRef] [PubMed]
- Durgapal, S.; Mukhopadhyay, S.; Goswami, L. Preparation, characterization and evaluation of floating microparticles of ciprofloxacin. Int. J. Appl. Pharm 2017, 9, 1–8. [Google Scholar] [CrossRef]
- Rathore, H.S.; Senthilvelan, T.; Vasantharaja, R.; Abraham, L.S.; Prakash, D.; Sivagnanam, U.T.; Gupta, S. Fabrication and characterization of chitosan film impregnated ciprofloxacin drug: A comparative study. Biocatal. Agric. Biotechnol. 2019, 18, 101078. [Google Scholar] [CrossRef]
- Dong, Z.; Wang, Q.; Du, Y. Alginate/gelatin blend films and their properties for drug controlled release. J. Membr. Sci. 2006, 280, 37–44. [Google Scholar] [CrossRef]
- Mudunkotuwa, I.A.; Al Minshid, A.; Grassian, V.H. ATR-FTIR spectroscopy as a tool to probe surface adsorption on nanoparticles at the liquid–solid interface in environmentally and biologically relevant media. Analyst 2014, 139, 870–881. [Google Scholar] [CrossRef] [PubMed]
- Cheng, Y.; Xu, W.; Chen, Z.; Wang, Z.; Huang, D. Micronization of etoposide using solution-enhanced dispersion by supercritical CO2. J. Supercrit. Fluids 2016, 115, 10–16. [Google Scholar] [CrossRef]
- Pentak, D. Physicochemical properties of liposomes as potential anticancer drugs carriers. Interaction of etoposide and cytarabine with the membrane: Spectroscopic studies. Spectrochim. Acta Part A Mol. Biomol. Spectrosc. 2014, 122, 451–460. [Google Scholar] [CrossRef]
- Németh, Z.; Csóka, I.; Semnani Jazani, R.; Sipos, B.; Haspel, H.; Kozma, G.; Kónya, Z.; Dobó, D.G. Quality by design-driven zeta potential optimisation study of liposomes with charge imparting membrane additives. Pharmaceutics 2022, 14, 1798. [Google Scholar] [CrossRef] [PubMed]
- Honary, S.; Zahir, F. Effect of zeta potential on the properties of nano-drug delivery systems-a review (Part 2). Trop. J. Pharm. Res. 2013, 12, 265–273. [Google Scholar]
- Park, S.N.; Jo, N.R.; Jeon, S.H. Chitosan-coated liposomes for enhanced skin permeation of resveratrol. J. Ind. Eng. Chem. 2014, 20, 1481–1485. [Google Scholar] [CrossRef]
- Mady, M.M.; Darwish, M.M. Effect of chitosan coating on the characteristics of DPPC liposomes. J. Adv. Res. 2010, 1, 187–191. [Google Scholar] [CrossRef]
- Paolino, D.; Sinha, P.; Fresta, M.; Ferrari, M. Drug Delivery Systems. In Encyclopedia of Medical Devices and Instrumentation; Wiley: Hoboken, NJ, USA, 2006. [Google Scholar]
- Zhang, J.; Xie, Z.; Zhang, N.; Zhong, J. Chapter 13—Nanosuspension drug delivery system: Preparation, characterization, postproduction processing, dosage form, and application. In Nanostructures for Drug Delivery; Andronescu, E., Grumezescu, A.M., Eds.; Elsevier: Amsterdam, The Netherlands, 2017; pp. 413–443. [Google Scholar]
- Abdelbary, G. Ocular ciprofloxacin hydrochloride mucoadhesive chitosan-coated liposomes. Pharm. Dev. Technol. 2011, 16, 44–56. [Google Scholar] [CrossRef]
- Olivera, M.E.; Manzo, R.H.; Junginger, H.E.; Midha, K.K.; Shah, V.P.; Stavchansky, S.; Dressman, J.B.; Barends, D.M. Biowaiver Monographs for Immediate Release Solid Oral Dosage Forms: Ciprofloxacin Hydrochloride. J. Pharm. Sci. 2011, 100, 22–33. [Google Scholar] [CrossRef] [PubMed]
- Mehanna, M.M.; Elmaradny, H.A.; Samaha, M.W. Mucoadhesive liposomes as ocular delivery system: Physical, microbiological, and in vivo assessment. Drug Dev. Ind. Pharm. 2010, 36, 108–118. [Google Scholar] [CrossRef] [PubMed]
- Almurshedi, A.S.; Aljunaidel, H.A.; Alquadeib, B.; Aldosari, B.N.; Alfagih, I.M.; Almarshidy, S.S.; Eltahir, E.K.D.; Mohamoud, A.Z. Development of inhalable nanostructured lipid carriers for ciprofloxacin for noncystic fibrosis bronchiectasis treatment. Int. J. Nanomed. 2021, 16, 2405–2417. [Google Scholar] [CrossRef]
- Fosca, M.; Rau, J.V.; Uskoković, V. Factors influencing the drug release from calcium phosphate cements. Bioact. Mater. 2022, 7, 341–363. [Google Scholar] [CrossRef]
- Lazaridou, M.; Nanaki, S.; Zamboulis, A.; Papoulia, C.; Chrissafis, K.; Klonos, P.; Kyritsis, A.; Vergkizi-Nikolakaki, S.; Kostoglou, M.; Bikiaris, D. Super absorbent chitosan-based hydrogel sponges as carriers for caspofungin antifungal drug. Int. J. Pharm. 2021, 606, 120925. [Google Scholar] [CrossRef]
- AlMajed, Z.; Salkho, N.M.; Sulieman, H.; Husseini, G.A. Modeling of the in vitro release kinetics of sonosensitive targeted liposomes. Biomedicines 2022, 10, 3139. [Google Scholar] [CrossRef] [PubMed]
- Ding, A.; Zhou, Y.; Chen, P.; Nie, W. Ibuprofen-loaded micelles based on star-shaped erythritol-core PLLA-PEG copolymer: Effect of molecular weights of PEG. Colloid Polym. Sci. 2017, 295, 1609–1619. [Google Scholar] [CrossRef]
- Vasileva, L.; Gaynanova, G.; Kuznetsova, D.; Valeeva, F.; Lyubina, A.; Amerhanova, S.; Voloshina, A.; Sibgatullina, G.; Samigullin, D.; Petrov, K.; et al. Mitochondria-Targeted Lipid Nanoparticles Loaded with Rotenone as a New Approach for the Treatment of Oncological Diseases. Molecules 2023, 28, 7229. [Google Scholar] [CrossRef]
- Jain, A.; Jain, S.K. In vitro release kinetics model fitting of liposomes: An insight. Chem. Phys. Lipids 2016, 201, 28–40. [Google Scholar] [CrossRef] [PubMed]
- Cipolla, D.; Blanchard, J.; Gonda, I. Development of Liposomal Ciprofloxacin to Treat Lung Infections. Pharmaceutics 2016, 8, 6. [Google Scholar] [CrossRef] [PubMed]
- Aranaz, I.; Mengíbar, M.; Harris, R.; Miralles, B.; Acosta, N.; Calderón, L.; Sánchez, Á.; Heras, Á. Role of physicochemical properties of chitin and chitosan on their functionality. Curr. Chem. Biol. 2014, 8, 27–42. [Google Scholar] [CrossRef]
- Sikora, M.; Wąsik, S.; Semaniak, J.; Drulis-Kawa, Z.; Wiśniewska-Wrona, M.; Arabski, M. Chitosan-based matrix as a carrier for bacteriophages. Appl. Microbiol. Biotechnol. 2024, 108, 6. [Google Scholar] [CrossRef] [PubMed]
- Wang, Y.; Wang, Z.; Lu, W.; Hu, Y. Review on chitosan-based antibacterial hydrogels: Preparation, mechanisms, and applications. Int. J. Biol. Macromol. 2024, 255, 128080. [Google Scholar] [CrossRef] [PubMed]
- Esposto, B.S.; Jauregi, P.; Tapia-Blácido, D.R.; Martelli-Tosi, M. Liposomes vs. chitosomes: Encapsulating food bioactives. Trends Food Sci. Technol. 2021, 108, 40–48. [Google Scholar] [CrossRef]
- Algan, A.H.; Gumustas, M.; Karatas, A.; Ozkan, S.A. A selective and sensitive stability-Indicating HPLC method for the validated assay of etoposide from commercial dosage form and polymeric tubular nanocarriers. J. Pharm. Biomed. Anal. 2016, 124, 382–389. [Google Scholar] [CrossRef]
- Zare Kazemabadi, F.; Heydarinasab, A.; Akbarzadeh, A.; Ardjmand, M. Preparation, characterization and in vitro evaluation of PEGylated nanoliposomal containing etoposide on lung cancer. Artif. Cells Nanomed. Biotechnol. 2019, 47, 3222–3230. [Google Scholar] [CrossRef]
- Robey, R.W.; Pluchino, K.M.; Hall, M.D.; Fojo, A.T.; Bates, S.E.; Gottesman, M.M. Revisiting the role of efflux pumps in multidrug-resistant cancer. Nat. Rev. Cancer 2018, 18, 452. [Google Scholar] [CrossRef]
- Ahmed, M.; Verreault, M.; Declèves, X.; Idbaih, A. Role of multidrug resistance in glioblastoma chemoresistance: Focus on ABC transporters. In Glioblastoma Resistance to Chemotherapy: Molecular Mechanisms and Innovative Reversal Strategies; Elsevier: Amsterdam, The Netherlands, 2021; pp. 243–261. [Google Scholar]
- Kryczka, J.; Boncela, J. Cell migration related to MDR—Another impediment to effective chemotherapy? Molecules 2018, 23, 331. [Google Scholar] [CrossRef]
- Fathi-Karkan, S.; Arshad, R.; Rahdar, A.; Ramezani, A.; Behzadmehr, R.; Ghotekar, S.; Pandey, S. Recent advancements in the targeted delivery of etoposide nanomedicine for cancer therapy: A comprehensive review. Eur. J. Med. Chem. 2023, 259, 115676. [Google Scholar] [CrossRef] [PubMed]
- Matsumura, Y.; Maeda, H. A new concept for macromolecular therapeutics in cancer chemotherapy: Mechanism of tumoritropic accumulation of proteins and the antitumor agent smancs. Cancer Res. 1986, 46, 6387–6392. [Google Scholar] [PubMed]
- Jinturkar, K.A.; Anish, C.; Kumar, M.K.; Bagchi, T.; Panda, A.K.; Misra, A.R. Liposomal formulations of Etoposide and Docetaxel for p53 mediated enhanced cytotoxicity in lung cancer cell lines. Biomaterials 2012, 33, 2492–2507. [Google Scholar] [CrossRef] [PubMed]
- Turabee, M.H.; Jeong, T.H.; Ramalingam, P.; Kang, J.H.; Ko, Y.T. N,N,N-trimethyl chitosan embedded in situ Pluronic F127 hydrogel for the treatment of brain tumor. Carbohydr. Polym. 2019, 203, 302–309. [Google Scholar] [CrossRef] [PubMed]
- Wimardhani, Y.S.; Suniarti, D.F.; Freisleben, H.J.; Wanandi, S.I.; Siregar, N.C.; Ikeda, M.A. Chitosan exerts anticancer activity through induction of apoptosis and cell cycle arrest in oral cancer cells. J. Oral Sci. 2014, 56, 119–126. [Google Scholar] [CrossRef] [PubMed]
- Choudhury, H.; Maheshwari, R.; Pandey, M.; Tekade, M.; Gorain, B.; Tekade, R.K. Advanced nanoscale carrier-based approaches to overcome biopharmaceutical issues associated with anticancer drug ‘Etoposide’. Mater. Sci. Eng. C 2020, 106, 110275. [Google Scholar] [CrossRef] [PubMed]
- Mati-Baouche, N.; Delattre, C.; de Baynast, H.; Grédiac, M.; Mathias, J.-D.; Ursu, A.V.; Desbrières, J.; Michaud, P. Alkyl-Chitosan-Based Adhesive: Water Resistance Improvement. Molecules 2019, 24, 1987. [Google Scholar] [CrossRef]
- Varan, C.; Bilensoy, E. Cationic PEGylated polycaprolactone nanoparticles carrying post-operation docetaxel for glioma treatment. Beilstein J. Nanotechnol. 2017, 8, 1446–1456. [Google Scholar] [CrossRef]
- Moin, I.; Biswas, L.; Zafaryab, M.; Kumari, N.; Leekha, A.; Mittal, D.; Verma, A. In vitro Toxico-genomics of Etoposide Loaded Gelatin Nanoparticles and Its in-vivo Therapeutic Potential: Pharmacokinetics, Biodistribution and Tumor Regression in Ehrlich Ascites Carcinoma (EAC) Mice Model. Front. Nanotechnol. 2021, 3, 624083. [Google Scholar] [CrossRef]
- Ensaf, P.K.; Goodarzi, M.T.; Tabrizi, M.H.; Neamati, A.; Hosseinyzadeh, S.S. Novel formulation of parthenolide-loaded liposome coated with chitosan and evaluation of its potential anticancer effects in vitro. Mol. Biol. Rep. 2024, 51, 369. [Google Scholar] [CrossRef]
- Zhu, L.; Li, R.; Jiao, S.; Wei, J.; Yan, Y.; Wang, Z.A.; Li, J.; Du, Y. Blood-Brain Barrier Permeable Chitosan Oligosaccharides Interfere with β-Amyloid Aggregation and Alleviate β-Amyloid Protein Mediated Neurotoxicity and Neuroinflammation in a Dose- and Degree of Polymerization-Dependent Manner. Mar. Drugs 2020, 18, 488. [Google Scholar] [CrossRef] [PubMed]
- Liu, C.; Gao, Y.; Zhao, L.; Wang, R.; Xie, F.; Zhai, G.; Liu, A. The development of a redox-sensitive curcumin conjugated chitosan oligosaccharide nanocarrier for the efficient delivery of docetaxel to glioma cells. Ann. Transl. Med. 2022, 10, 297. [Google Scholar] [CrossRef] [PubMed]

| Sample | CS (%) | Cholesterol (%) | CFX (mg/mL) | Eto (mg/mL) |
|---|---|---|---|---|
| SUVs | - | - | - | - |
| SUVs-CS | 0.3 | - | - | - |
| CholSUVs | - | 5.6 | - | - |
| CholSUVs-CS | 0.3 | 5.6 | - | - |
| CFX-SUVs | - | - | 0.3 | - |
| CFX-SUVs-CS | 0.3 | - | 0.3 | - |
| Eto-CholSUVs | - | 5.6 | - | 0.2 |
| Eto-CholSUVs-CS | 0.3 | 5.6 | - | 0.2 |
| Release Mechanism | Hindered Fickian Diffusion | Fickian Diffusion | Anomalous Transport | Non-Fickian Transport | Super Case II |
|---|---|---|---|---|---|
| Diffusional exponent, n | n < 0.43 | n = 0.43 | 0.43 < n < 0.85 | n = 0.85 | n > 0.85 |
| Sample | Day | Diameter (nm) | PDI | Zeta Potential (mV) |
|---|---|---|---|---|
| SUVs | 1 | 88.58 ± 0.51 | 0.238 | +27.7 ± 0.557 |
| 7 | 89.32 ± 1.12 | 0.236 | +26.3 ± 1.51 | |
| SUVs-CS | 1 | 194 ± 1.33 | 0.454 | +44 ± 1.86 |
| 7 | 195.8 ± 1.41 | 0.439 | +48.9 ± 0.81 | |
| CFX-SUVs | 1 | 87.53 ± 0.13 | 0.244 | +24.2 ± 1.16 |
| 7 | 86.03 ± 0.15 | 0.230 | +28.6 ± 1.21 | |
| CFX-SUVs-CS | 1 | 197.3 ± 1.26 | 0.477 | +44.8 ± 2.5 |
| 7 | 194.1 ± 1.15 | 0.445 | +40.2 ± 1.44 |
| Sample | Day | Diameter (nm) | PDI | Zeta Potential (mV) |
|---|---|---|---|---|
| CholSUVs | 1 | 93.18 ± 0.26 | 0.209 | +30.3 ± 1.31 |
| 7 | 93.58 ± 0.627 | 0.207 | +27.6 ± 0.379 | |
| CholSUVs-CS | 1 | 203.2 ± 2.76 | 0.462 | +48.6 ± 0.81 |
| 7 | 182.2 ± 1.973 | 0.410 | +49.8 ± 2.12 | |
| Eto-CholSUVs | 1 | 323.1 ± 17.73 | 0.781 | +26 ± 0.25 |
| 7 | 1309 ± 88.88 | 0.717 | +10.7 ± 0.25 | |
| Eto-CholSUVs-CS | 1 | 689 ± 16.72 | 0.638 | +37.6 ± 1.27 |
| 7 | 688.5 ± 26.08 | 0.599 | +39 ± 0.7 |
| Model | Equation | CFX-SUVs | CFX-SUVs-CS | ||
|---|---|---|---|---|---|
| Equation | R2 | Equation | R2 | ||
| Korsmeyer–Peppas | Ct/CT = k · tn | y = 0.404x + 3.248 | 1 | y = 0.534x + 2.750 | 0.963 |
| First Order | dC/dt = k · (Cs – Ct) | y = 0.030x + 3.753 | 0.877 | y = 0.026x + 3.571 | 0.744 |
| Higuchi | Ct/CT = k · t1/2 | y = 18.954x | 0.994 | y = 15.257x | 0.994 |
| Baker–Lonsdale | Ct/CT − 1,5 · [1 − (1 − Ct/CT)2/3] = k · t | y = −0.0118x | 0.997 | y = −0.0068x | 0.997 |
| Weibull | Ln[ln(1/(1 − Ct/CT)] = βln(t) + ln(α) | y = 0.748x − 1.577 | 0.970 | y = 0.738x − 1.949 | 0.985 |
Disclaimer/Publisher’s Note: The statements, opinions and data contained in all publications are solely those of the individual author(s) and contributor(s) and not of MDPI and/or the editor(s). MDPI and/or the editor(s) disclaim responsibility for any injury to people or property resulting from any ideas, methods, instructions or products referred to in the content. |
© 2024 by the authors. Licensee MDPI, Basel, Switzerland. This article is an open access article distributed under the terms and conditions of the Creative Commons Attribution (CC BY) license (https://creativecommons.org/licenses/by/4.0/).
Share and Cite
Gil-Gonzalo, R.; Durante-Salmerón, D.A.; Pouri, S.; Doncel-Pérez, E.; Alcántara, A.R.; Aranaz, I.; Acosta, N. Chitosan-Coated Liposome Formulations for Encapsulation of Ciprofloxacin and Etoposide. Pharmaceutics 2024, 16, 1036. https://doi.org/10.3390/pharmaceutics16081036
Gil-Gonzalo R, Durante-Salmerón DA, Pouri S, Doncel-Pérez E, Alcántara AR, Aranaz I, Acosta N. Chitosan-Coated Liposome Formulations for Encapsulation of Ciprofloxacin and Etoposide. Pharmaceutics. 2024; 16(8):1036. https://doi.org/10.3390/pharmaceutics16081036
Chicago/Turabian StyleGil-Gonzalo, Rubén, D. Alonzo Durante-Salmerón, Saeedeh Pouri, Ernesto Doncel-Pérez, Andrés R. Alcántara, Inmaculada Aranaz, and Niuris Acosta. 2024. "Chitosan-Coated Liposome Formulations for Encapsulation of Ciprofloxacin and Etoposide" Pharmaceutics 16, no. 8: 1036. https://doi.org/10.3390/pharmaceutics16081036
APA StyleGil-Gonzalo, R., Durante-Salmerón, D. A., Pouri, S., Doncel-Pérez, E., Alcántara, A. R., Aranaz, I., & Acosta, N. (2024). Chitosan-Coated Liposome Formulations for Encapsulation of Ciprofloxacin and Etoposide. Pharmaceutics, 16(8), 1036. https://doi.org/10.3390/pharmaceutics16081036

